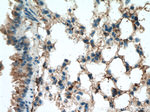
Beta-2-microglobulin Antibody in Immunohistochemistry (Paraffin) (IHC (P))

Search
Proteintech
Beta-2-microglobulin Polyclonal Antibody
{{$productOrderCtrl.translations['antibody.pdp.commerceCard.promotion.promotions']}}
{{$productOrderCtrl.translations['antibody.pdp.commerceCard.promotion.viewpromo']}}
{{$productOrderCtrl.translations['antibody.pdp.commerceCard.promotion.promocode']}}: {{promo.promoCode}} {{promo.promoTitle}} {{promo.promoDescription}}. {{$productOrderCtrl.translations['antibody.pdp.commerceCard.promotion.learnmore']}}
产品信息
13511-1-AP
种属反应
已发表种属
宿主/亚型
分类
类型
抗原
偶联物
形式
浓度
规格
纯化类型
保存液
内含物
保存条件
运输条件
产品详细信息
Immunogen sequence: QRTPKIQVY SRHPAENGKS NFLNCYVSGF HPSDIEVDLL KNGERIEKVE HSDLSFSKDW SFYLLYYTEF TPTEKDEYAC RVNHVTLSQP KIVKWDRDM (22-119 aa encoded by BC032589)
靶标信息
Beta-2-microglobulin (B2M) is a 12-14 kDa protein that is a subunit of the major histocompatibility complex (MHC) class I. Human beta 2 Microglobulin associated with HLA Class I antigens are expressed on many types of cells including lymphocytes, thymocytes, monocytes, granulocytes, platelets, endothelial cells, and epithelial cells, but is absent on erythrocytes. Beta-2 microglobulin is also found in free form in the plasma. The amino acid sequence of Beta-2-microglobulin is homologous to the constant regions of immunoglobulin heavy and light chains, with a predominantly beta pleated sheet structure. The protein is ubiquitously expressed in the cytoplasm, and is involved in antigen processing and presentation. Beta-2-microglobulin also plays a role in TCR signaling, and downstream signaling in naive CD8+ cells. Beta 2-microglobulin is encoded by the B2M gene located on chromosome 15. A mutation in the Beta-2-microglobulin gene has been shown to result in hypercatabolic hypoproteinemia. Levels of beta 2 microglobulin can be used to assess renal function in kidney transplant recipients. Beta-2-microglobulin that protein can be used as a prognostic marker for HIV infection.
仅用于科研。不用于诊断过程。未经明确授权不得转售。
生物信息学
蛋白别名: B-F; B2-microglobulin; B2M; Beta 2 microglobin; Beta 2 microglobulin; beta 2-microglobulin; beta chain of MHC class I molecules; beta-2-microglobin; Beta-2-microglobulin; beta-2-microglobulin C-terminal fragment (55 AA); Beta2 microglobulin; HDCMA22P; MHC Class I; microglobulin beta-2; Orla-B2m; similar to Homo sapiens mRNA for beta 2-microglobulin with GenBank Accession Number AB021288; unnamed protein product
基因别名: AMYLD6; B2M; beta2-m; beta2m; CDABP0092; HDCMA22P; IMD43; Ly-m11; MHC1D4
UniProt ID: (Human) P61769, (Mouse) P01887, (Rat) P07151
Entrez Gene ID: (Human) 567, (Mouse) 12010, (Rat) 24223